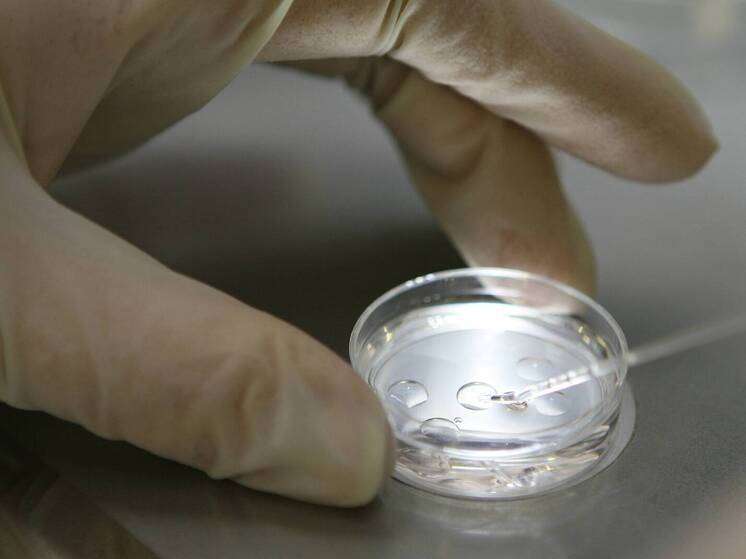

тестовый баннер под заглавное изображение
Впервые новое научное исследование предоставило генетические доказательства, указывающие на то, что Христофор Колумб происходил из галисийской знати в Испании и, в частности, из рода Сотомайор. Спустя пять столетий после первого путешествия в Америку вопрос о том, кем на самом деле был Христофор Колумб, остается без ответа.
Официальная версия гласит, что Колумб родился в Генуе, был мореплавателем, который убедил католических монархов профинансировать то, что никто не считал возможным, однако эта история на протяжении десятилетий подвергалась сомнению историками, лингвистами и, совсем недавно, генетиками. Они взяли генетический материал из склепа в Гельвеше, где похоронены по меньшей мере семь прямых потомков исследователя. Его выводы, которые еще не были рассмотрены экспертами, указывают на галисийского дворянина Педро Альвареса де Сотомайора, известного как Педро Мадруга, как на прямого предка колумбийской линии.
Все началось с информации, которая никак «не сходилась»: проанализировав ДНК 12 человек, эксгумированных из фамильного склепа графов Гельвес, исследователи обнаружили, что у двоих из них был общий генетический материал, хотя исторические документы, подтверждающие это родство, отсутствовали. Одним из них был Хорхе Альберто Португальский, третий граф Гелвеш и праправнук Колумба, а другим — Мария де Кастро Хирон Португальская, графиня-консорт 17-го века, которая вошла в эту семью по браку и происходила из Галисии, будучи дочерью 9-го графа Лемоса. Тот факт, что у двух людей, не имеющих документально подтвержденного родства, есть общая ДНК, может быть объяснен только одним способом: у них есть общий предок, которого нет в записях. Команда применила вычислительную модель к 16 поколениям генеалогий, чтобы идентифицировать этого человека, и анализ, по мнению авторов, однозначно указывал на Педро Альвареса де Сотомайора.
Чтобы подтвердить это, они прибегли к так называемой технике виртуального нокаута: когда они фактически вычеркнули Педро Мадругу из генеалогического древа, генетическая связь между двумя особями исчезла, тогда как ни один другой предок из сотен проанализированных не смог показать такого же эффекта. Генетик Изабель Наварро-Вера использовала массовое параллельное секвенирование более чем 10 тысяч генетических маркеров, отметив, что эта техника ранее не применялась к таким древним останкам. Гипотеза о том, что Колумбом мог быть Педро Альварес де Сотомайор или его сын, не нова: впервые она была сформулирована историком Сельсо Гарсиа де ла Риега из Понтеведры в начале 20-го века, а причиной ее сохранения была не столько убежденность сторонников, сколько совокупность совпадений, которые никому не удалось полностью объяснить. Педро Мадруга был одним из самых могущественных феодалов Галисии 15-го века, он контролировал обширную территорию из замка Сотомайор, участвовал в гражданских войнах в Кастилии, заключал договоры с Португалией и конфликтовал с католическими монархами, а около 1486 года бесследно исчез из исторических документов. В том же году Христофор Колумб впервые предстал перед двором Изабеллы и Фердинанда, и суть теории заключается в хронологии: один уходит, а другой появляется, при этом их документально подтвержденные жизни никогда не пересекаются.
В дополнение к этому есть и другие подсказки: тексты Колумба содержат синтаксические конструкции, типичные для галисийско-португальского языка, а герб, пожалованный ему католическими монархами, украшен золотыми лентами, которые являются частью традиционной геральдики Сотомайоров, и к нему с самого начала относились при дворе как к человеку, которого уже знали. Сами авторы препринта тщательно выверяют свои выводы, признавая, что это косвенное свидетельство, полученное от потомков, а не от ДНК самого Колумба, и что их результаты требуют независимой проверки.
Итальянская гипотеза по-прежнему является доминирующей в историографии, и сам Колумб в своем завещании от 1498 года указал, что родился в Генуе, однако защитники галицийской теории отвечают, что человек, который десятилетиями скрывал свое прошлое, не раскроет его в конце своей жизни. Что изменилось, так это качество доступных инструментов, и данное исследование, несмотря на все его ограничения, является первым геномным доказательством, подтверждающим происхождение Колумба от знати северной Испании.